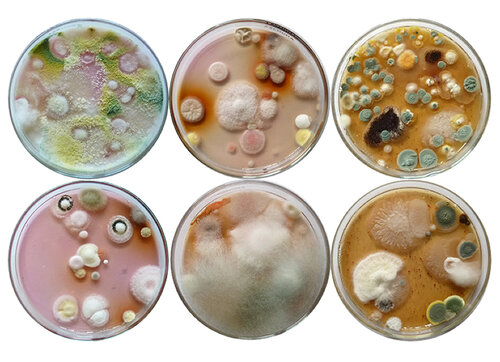

Ochrana přírody 5/2021 — 28. 10. 2021 — Z naší přírody — Tištěná verze článku v pdf
– významná komponenta půdní mikrobioty
Mikroedafon představuje velice významnou a nezbytnou složku všech půd. Zahrnuje mikroskopické živočichy, v povrchové vrstvě půdy se nacházejí autotrofní organismy (řasy a cyanobakterie), chemoautotrofní organismy (některé archea a bakterie) a hlavně heterotrofní organismy (bakterie včetně aktinobakterií a houby). Heterotrofní houby a bakterie představují ekologickou skupinu dekompozitorů, která má obrovský význam v koloběhu uhlíku a dalších prvků v přírodě. Jejich rozkladná činnost v půdě je pro život na Zemi zásadní, účastní se rozkladu mrtvé organické hmoty rostlinného, živočišného i mikrobiálního původu a jejich činností vznikají humusové látky, které jsou nezbytné pro úrodnost půd. Postupným rozkladem těchto komponent jsou do půdy uvolňovány chemické prvky potřebné pro růst rostlin.
Hlavní skupiny půdních hub
Půdní houby představují vzhledem ke své biomase a fyziologické aktivitě nejvýznamnější skupinu (je známo, že délka mycelia v 1 g půdy je v rozmezí několika metrů až kilometrů v závislosti na typu půdy), zatímco nejpočetnější skupinou půdní mikrobioty jsou bakterie. Bakterie a houby spolu soutěží o substrát a s tím souvisí i produkce sekundárních metabolitů jimi do půdy uvolňovaných.

Ukázka druhové pestrosti půdních mikroskopických hub – 10denní kolonie
izolovaných mikroskopických hub na sladinovém agaru. Foto Alena Nováková
Půdní houby sensu lato představují všechny druhy hub žijící v půdě. Půda je jejich životním prostředím, rezervoárem jejich spor čekajících na vhodné podmínky pro vyklíčení nebo alespoň v tomto prostředí probíhá část jejich životního cyklu. Bohaté spektrum půdních hub zahrnuje několik ekologických skupin hub.
První z nich jsou parazitické houby, obligátní i fakultativní parazité rostlin, živočichů včetně člověka, ale také mykoparazitické houby, tj. houby parazitující na jiných houbách. Tyto houby se mohou vyskytovat v půdě pouze ve formě spor, které čekají na vhodného hostitele, ale některé druhy parazitických hub jsou schopné růstu ve formě saprotrofní fáze jejich životního cyklu (saprotrofie je využívání mrtvé organické hmoty rostlinného, živočišného nebo mikrobiálního původu jako zdroje energie a živin pro svůj růst) a v parazitickou fázi přecházejí při kontaktu s patřičným hostitelem. Do této skupiny hub také patří oportunní houby, tedy druhy hub, které jsou běžně saprotrofní, ale za určitých podmínek mohou přejít k parazitaci.
Petriho misky s koloniemi mikroskopických hub izolovaných zřeďovací
metodou z půdních vzorků odebraných na výsypkách po těžbě uhlí. Foto Alena Nováková
Další skupinou hub vyskytující se v půdě jsou rhizosférní a rhizoplánní houby. Tyto houby žijí v blízkosti kořenů rostlin (rhizosférní houby) nebo přímo na jejich povrchu (rhizoplánní druhy). Druhové složení těchto skupin hub je odlišné od hub ve volné půdě vzhledem k přítomnosti specifických látek produkovaných kořeny rostlin (kořenové výměšky).
Mykorhizní houby představují další skupinu půdních hub. Zástupci této skupiny žijí v symbióze s kořeny rostlin, ve stavu výhodném pro obě strany. Podle toho, zda kořeny obrůstají a vytvářejí na jejich povrchu spleť myceliálních vláken („myceliální punčošku“) a pronikají do kořenů jen pomocí speciálních hyf, nebo naopak výrazně prorůstají do kořenů rostlin a vytvářejí uvnitř jejich buněk speciální útvary, rozeznáváme ektomykorhizní a endomykorhizní houby. V půdách se také vyskytuje mycelium saprotrofních makromycetů (vřeckovýtrusých a stopkovýtrusých hub), jejichž reprodukční orgány (plodnice) nacházíme na povrchu půdy stejně jako u většiny mykorhizních hub.

Penicillium vulpinum patří mezi nejkrásnější půdní mikroskopické houby.
a – desetidenní kolonie na sladinovém agaru, b, c – detail kolonie s typicky
tvarovanými synnematy. Foto Alena Nováková
Velice specifickou a nesmírně zajímavou skupinu půdních hub představují tzv. houby-predátoři. Tyto houby se specializují na odchyt různých půdních živočichů a vytvářejí za tímto účelem speciální útvary ve tvaru sítěk, ok apod., do kterých živočichy chytají.
Entomopatogenní houby, např. druhy rodů Beauveria, Isaria, Cordyceps, Metarhizium a Verticillium sensu lato, jsou schopné dlouhodobě růst v půdě a napadat různé zástupce hmyzu. Po napadení hmyzu většinou dochází k jeho usmrcení a kutikulou posléze prorůstají různě tvarovaná synnemata nebo jednotlivé konidiofory. Tyto houby jsou proto často využívány při biologické ochraně rostlin.
Další skupinou jsou koprofilní houby, tedy druhy přednostně rostoucí na exkrementech živočichů nebo v půdách znečištěných exkrementy, ale bývají často izolovány z půdního prostředí. Exkrementy ve formě trusu savců, ptáků atd. se nacházejí hlavně na povrchu půdy, ale v půdě se nachází i značné množství na první pohled neviditelných fekálních peletek bezobratlých půdních živočichů, které jsou zdrojem živin pro koprofilní druhy hub. Fekální peletky obsahují specifické látky, jimiž je organický materiál obohacen při průchodu střevním traktem a které se ve volné půdě nevyskytují.

a – detail kolonie Penicillium clavigerum s prstovitými synnematy, b – kolonie P. scabrosum,
c – kolonie entomopatogenní houby Cordyceps fumosorosea. Foto Alena Nováková
Poslední skupinou jsou pravé půdní houby (nebo také půdní houby sensu stricto), saprotrofní mikroskopické vláknité houby a kvasinky. A právě tyto houby se spolu s půdními bakteriemi účastní procesu dekompozice organické hmoty v půdě. V průběhu tohoto procesu dochází k tvorbě půdního humusu a huminových a fulvinových kyselin a k postupnému rozkladu organických látek různého původu až na základní anorganické sloučeniny využitelné rostlinami. V rámci těchto půdních mikromycet rozlišujeme např. primární a sekundární cukerné, celulolytické a lignikolní druhy hub. Všechny tyto druhy soutěží s ostatními zástupci saprotrofní půdní mikrobioty (bakterie a aktinobakterie) o substrát a účastní se sukcese při rozkladu mrtvé organické hmoty. Mikroskopické saprotrofní houby hrají v rozkladných procesech velkou roli a díky myceliu, které produkuje mnohem větší množství enzymů než buňky bakterií a které má i mnohem větší absorpční schopnost. Obecně je známo, že mikroskopické houby při rozkladu látek transportují do mycelia více než 50 % rozložených látek, zatímco u bakterií je to jen 20 % těchto látek. Tvorba humusu a mineralizace organických látek je primární funkcí mikroskopických hub v půdě. Další neméně významnou aktivitou půdních mikromycet je produkce různých sloučenin, sekundárních metabolitů, které uplatňují v kompetičním boji o substrát (různé mykotoxiny a antibiotika). Samozřejmě obdobné látky s antibiotickými vlastnostmi produkují i bakterie, které se tím snaží zamezit houbám v jejich činnosti v půdě a mohou vyvolávat přítomností těchto látek v půdě jak exogenní dormanci (nemožnost spor klíčit), tak fungistázi (zamezení růstu mycelia). Půdní mikroskopické houby jsou také potravou pro řadu půdních bezobratlých živočichů. Někteří z nich také napomáhají šíření těchto hub v půdě zachycením spor na povrchu těl, a některé spory jsou aktivovány právě po průchodu střevním traktem těchto živočichů. V neposlední řadě se půdní mikromycety podílejí na tvorbě mikrostruktury půdy, kdy tvorbou hyf splétají mikročástice, ale mohou také ovlivnit vsakování vody a vodoodpudivé vlastnosti půdy produkcí hydrofóbních proteinů.
Houby jsou v půdě přítomné ve formě jedno- až mnohobuněčných spor, vytvářejí také mnohobuněčné a mohutně větvené mycelium, sklerotia, chlamydospory, pyknidy, a některé dokonce i plodnice (kleistotécia a gymnotécia). Nejvíce je houbami osídlena povrchová vrstva půdy, kde je pro ně nejvíce využitelné organické hmoty, ale řada hub roste také v minerálním horizontu i ve značné hloubce.

Nedávno popsaný druh Aspergillus europeus se vyskytuje v půdách řady
evropských zemí, 7denní kolonie na CYA.
Foto Alena Nováková
K metodám studování hub
První izolaci půdních hub se získáním jejich kultur provedl v roce 1886 německý badatel Adametz. V té době však byla ještě půda považována pouze za rezervoár spor hub, stejně tak jako tomu bylo na začátku 20. století. Teprve zdokonalením izolačních a kultivačních metod započalo důkladné studium půdních mikrobiot včetně hub. Bylo studováno nejen druhové zastoupení hub v různých typech půd a v půdním profilu, vliv rostlinného pokryvu, klimatických vlivů atd. na přítomnost hub v půdách. Zdokonalováním studijních metod se měnil i názor na půdní houby – získané výsledky řady studií ukázaly, že houby se v půdě nevyskytují jen ve formě spor, ale vytvářejí bohaté mycelium, které se účastní různých rozkladných procesů probíhajících v půdě.
Použitím různých izolačních metod – od klasické zřeďovací metody, kterou je více než 90 % izolovaných druhů izolováno ze spor, a různých modifikací zřeďovací metody, přímé izolace, izolace pomocí různých záchytných metod či částečné sterilizace nebo filtrace po promývací metodu, která naopak umožňuje zachytit z půdy druhy vyskytující se ve formě mycelia – a samozřejmě nezbytnou kombinací různých izolačních médií se ukázalo, že v půdách je skutečně široké spektrum půdních mikromycet zahrnující druhy z oddělení Mucoromycota, Ascomycota a Basidiomycota. Zástupci rodů Penicillium, Talaromyces, Trichoderma, Fusarium, Absidia, Mucor, Mortierella, Clonostachys, Cladosporium a v teplejších oblastech také Aspergillus patří mezi nejčastěji izolované druhy saprotrofních mikromycet.
Různé typy půd, stejně tak půdy s různým vegetačním krytem nebo jednotlivé půdní horizonty, se liší jak kvantitativním, tak druhovým zastoupením půdních mikromycet. Izolace mikroskopických hub včetně získání čistých kultur a determinace izolovaných druhů je dlouhodobý proces náročný na čas, materiál i prostor. Přesto se kombinací izolačních metod a různých izolačních médií nepodaří izolovat všechny druhy mikromycet, které se v půdě nacházejí – některé druhy jsou např. ve stavu dormance, případně fungistáze, a nepodaří se je zachytit. Navíc půda je skutečně velice heterogenní systém, plný velkého množství mikroprostor lišících se jak podmínkami, tak osídlením, a z tohoto důvodu je pro zvýšení záchytnosti nezbytné současně izolovat z většího množství vzorků odebraných z jedné lokality a izolace opakovat v průběhu několika let. Použití environmentálních molekulárních analýz přináší zcela odlišné a bohatší spektrum hub, ale bez možnosti izolace těchto hub.
Co ovlivňuje zastoupení půdních hub?
Jakékoliv změny v půdním prostředí, ať už způsobené nepříznivými klimatickými podmínkami, jako například zamokření půd po přívalových deštích, nebo naopak kompletní vysušení půdy následkem dlouhodobého sucha, tak změny následkem lidské činnosti (chemické postřiky, zhutnění půd následkem použití těžké zemědělské techniky, zamokření nebo nadměrné vysušení půd následkem nevhodného hospodaření apod.) vedou k celé řadě změn v kvantitativním i kvalitativním zastoupení jednotlivých složek edafonu. Tím dochází i ke zcela zásadním změnám v zastoupení půdních hub. Např. aplikací herbicidů dochází k sérii změn v zastoupení různých skupin edafonu – není ovlivněn jen rostlinný pokryv půdy, ale změní se také vlhkost půdy, a přestože je použitá chemikálie primárně cílena na zničení rostlinného pokryvu, může usmrtit i některé půdní organismy. Snížením počtu či vymizením byť jedné skupiny edafonu dochází k následným změnám u dalších skupin živočichů i mikrobioty. V případě hub tak např. může změna v zastoupení mykofágních živočichů vyvolat následnou změnu v kvantitativním zastoupení hub i jejich druhového složení a tím ovlivnit jak rozkladné procesy probíhající v půdě v důsledku porušení interakcí mezi bakteriemi a houbami, tak zpětně také jednotlivé složky edafonu (změna potravní nabídky).
Jak chránit půdy
Ochrana půd by měla být zaměřena také na ochranu živé složky půdy – edafonu. Bez tohoto křehkého společenstva půdních organismů by půda nebyla půdou, ale mrtvým substrátem. Díky dlouhodobé dynamické rovnováze, v níž se půda nachází, má poměrně vysokou odolnost, díky níž dokáže poměrně dlouho odolávat nepříznivým faktorům. Na odolnosti půdy vůči řadě nepříznivých faktorů i na zachování její úrodnosti působí příznivě zejména obsah půdní organické hmoty, ale i pufrační schopnost půdy má své meze. Na dlouhodobé zachování kvality půdy, zejména obsahu humusu, má velký vliv rozumné obhospodařování a omezené používání pesticidů. Pro zachování regionální biodiverzity půdy mohou sloužit remízky a malé rezervace, odkud se mohou šířit spory saprotrofních hub do okolních agroekosystémů a omezovat tak např. pronikání různých fytopatogenních hub.